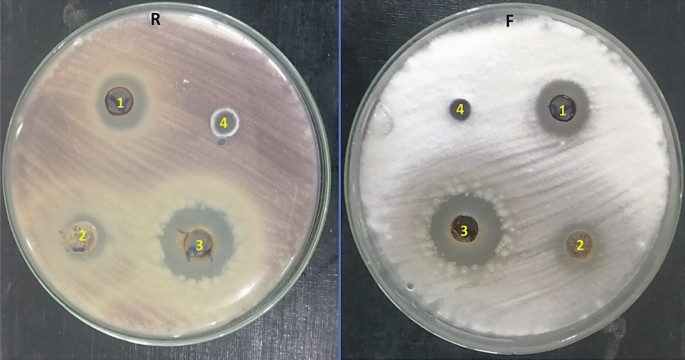

- Original Article
- Open access
- Published:
Biostimulation of tomato growth and biocontrol of Fusarium wilt disease using certain endophytic fungi
Botanical Studies volume 63, Article number: 34 (2022)
Abstract
Background
Tomato plant (Solanum lycopersicum L.) suffers from numerous fungal pathogens that cause damage to yeild production qualitatively and quantitatively. One of the most destructive disease of tomato is Fusarium wilt that caused by soil borne fungus called F. oxysporum.
Methods
In this study, the anti-Fusarium capabilities of the foliar application of fungal endophytes extracts have been investigated on tomato under Fusarium challenges. Antifungal assay, inhibition of conidial germination, disease severity, photosynthetic pigments, osmolytes, secondary metabolites, oxidative stress, peroxidase (POD) and polyphenol oxidases (PPO) isozymes were tested for potential resistance of tomato growing under Fusarium infection.
Results
Ethyl acetate extracts of A. flavus MZ045563, A. fumigatus MZ045562 and A. nidulans MZ045561 exhibited antifungal activity toward F. oxysporum where inhibition zone diameters were 15, 12 and 20 mm, respectively. Moreover, extracts of all fungal isolates at concentration 7.5 mg/mL reduced conidia germination from 94.4 to 100%. Fusarium infection caused a destructive effects on tomato plant, high severity desiese index 84.37%, reduction in growth parameters, photosynthetic pigments, and soluble protein. However, contents of proline, total phenol, malondialdehyde (MDA), hydrogen peroxide (H2O2) and antioxidant enzymes activity were increased in tomato plants grown under Fusarium wilt. Treatment of healthy or infected tomato plants by ethyl acetate fungal extracts showed improvements in morphological traits, photosynthetic pigments, osmolytes, total phenol and antioxidant enzymes activity. Besides, the harmful impacts of Fusarium wilt disease on tomato plants have also been reduced by lowering MDA and H2O2 levels. Also, treated tomato plants showed different responses in number and density of POD and PPO isozymes.
Conclusion
It could be suggested that application of ethyl acetate extracts of tested fungal endophytes especially combination of A. flavus, A. nidulans and A. fumigatus could be commercially used as safe biostimulation of tomato plants as well as biofungicide against tomato Fusarium wilt disease.
Introduction
Agricultural crops suffered from many risks as biotic stresses including fungal pathogens that are increasing day by day in light of climatic extremes (Hashem et al. 2021). In addition to plant pathogens whose virulence is increasing and leading to severe damages that lead to crop failure and the formation of microbial toxins inside the final product, which harms the life of the final consumer (Jackson and Taylor 1996; Khalil et al. 2019; Abdelaziz et al. 2022a).The Solanaceae family is exposed to many pathogens that cause decreasing in productivity. Tomato is a short-lived perennial cropped as annual, and it is part of the Solanaceae and is usually grown for its edible fruits. Tomato considers among the important crops grown over the world for their economic and nutritional value. Tomato is an economical plant widely cultivated all over the world (Olatunji and Afolayan 2018). Fusarium is one of the most common fungi and is found in agricultural soils, whether they are cultivated organically or conventionally thus it classified as soil borne fungus (Elmholt 1996; Abdelaziz et al. 2022b). Tomato crops are being reduced all over the world, including Egypt, due to soil-borne diseases such as F. oxysporum, Alternaria that cause significant losses in productivity quantity and quality (Attia et al.2022a, b, c). There are many biological, natural and chemical inducers can Induce plant resistance against biotic stresses (Abdelaziz et al. 2022c; Khattab et al. 2022).
Plant growth promoting fungi (PGPF) applied as effective natural control against phytopathogens including F. oxysporum and improved the tomato plant growth through encourage biochemical resistance and improve the effectiveness of tomato resistance against phytopathogens including Fusarium spp. (Hyakumachi 2013). This biochemical defence activated by certain fungal metabolites as HCN, IAA, siderophore and by increasing plant ability to solubilize phosphate (Chakraborty et al. 2006; Attia et al. 2022a, b, c). Endophytes are microorganisms that exist in living healthy plant tissues without producing any diseased symptoms to their host plants. Endophytic fungi are very important type of endophytes that hyperdiverse (Wani et al. 2015; Khalil et al. 2021). Recently, scientists have received much attention about isolation of endophytes and the study of their natural products. plants harbor a numerous of endophytic microorganisms, owning huge metabolic diversity and varied bioactive substances that can be applied as a therapeutic toll against human pathogens as well as biotic and a biotic stresses of plants (Nisa et al. 2015, Strobel, 2018, Aldinary et al. 2021, Badawy et al. 2021, Hashem et al. 2022). Ethyl acetate extract derivative from endophytic fungi have a great activity against diverse pathogenic microorganisms due to the occurrence of active secondary metabolites including steroids, flavonoids, terpenoids, peptides, quinones, lignans, alkaloids, phenylpropanoids, phenolics and isocoumarins (Elghaffar et al. 2022).
This study aims to evaluate the anti-fungal capabilities of ethyl extracts of endophytic fungi (A. flavus, A. nidulance, A. fumigatus) on tomato plants under Fusarium infection and evaluate the promotion activity of healthy tomato plants through a safe and ecofriendly method.
Materials and methods
Source of endophytic fungi
Endophytic fungi isolated from healthy Ocimum Basilicum then identified as A. flavus MZ045563, A. fumigatus MZ045562 and A. nidulans MZ045561 in our previous study (Sharaf et al. 2022).
Source of the fungal pathogen
F.oxysporum f. sp. Lycopersici RCMB008001 was purchased from Regional Center for mycology at Al-Azhar University (RCMB) then was established by pathogenicity test according to Hibar et al. (2007). The inoculum was prepared according to Büttner et al. (2004).
Extraction of bioactive compounds from fungi
Endophytic fungi were cultured in potato dextrose broth medium (PDB) (Oxoid) at 27 ℃ ± 2 ℃ for 21 days under static conditions. The fermentation broth was subjected to filtration under septic conditions to remove fungal mycelia. Culture filtrates of the isolated fungal endophytes were extracted twice using ethyl acetate (EtOAc) (1:1); 100 mL from each filtrate was mixed with 100 mL of ethyl acetate and placed on a vortex shaker for 10 min and settled down for 5 min until the two clear separate layers were formed. The organic layer (EtOAc) was separated from the aqueous layer by the separating funnel. The collected organic phase was evaporated under reduced pressure at 40–45 ℃ using a rotary evaporator (Heidolph VV2001, Germany); DMSO at 1 mg/mL of concentration was used to dissolve the fungal crude extract and then stored at – 20 ℃ until further experiments (Supaphon et al. 2013).
Antifungal assay
The antifungal activity of crude extract of fungal isolates was investigated on potato dextrose agar (PDA) against F. oxysporum according to Sharaf et al. (2022). The conidia of F. oxysporum were cultivated on the surface of PDA medium and incubated at 25 °C for 10 days. Then, the culture of F. oxysporum was surface flooded with 10 mL of sterilized water to obtain the suspension of fungal conidia which adjusted to around 105 conidia/mL by diluting and counting. Sterile Petri dishes (120 mm) containing PDA media were inoculated with 100 µL of F. oxysporum conidial suspension. Then agar wells (8 mm) were cut using sterile cork borer and loaded with 100 µL of the crude extract of fungal isolates (5 mg/mL) as well as fluconalzole (25 µg/well) which used as antifungal control. After incubation of inoculated PDA plates at 25 °C for 5 days and the resulted inhibition zone diameter (mm) were measured and represented as mean ± standard error values. The experiment was performed in triplicates.
Inhibition of conidial germination assay
A suspension of 10 days old F. oxysporum conidia was prepared as previously mentioned in the antifungal assay. In this assay, the effects of endophytic fungi crude extracts on F. oxysporum conidial germination were examined at varieing concentrations (2.5, 5 and 7.5 mg/mL) as performed by Rongai et al. (2012) with some modifications. Each well of the microtiter plate received 200 μL of a combination containing: 80 μL of conidial suspension, 100 μL of double strength PDB, and 20 μL of the tested fungal crude extract. Each treatment was carried out in three wells, with one plate row containing an untreated spore suspension in PDB as a negative control. Conidial germination was determined by mounting 10 μL samples of each treatment on a hemocytometer slide after 24, 48, and 72 h and counting the number of germinated and non-germinated spores in five squares at 200 × magnification. The percentage of germination was determined and averaged for the three wells using the following equation:
Pot experiment
Four weeks of age tomato seedlings were obtained from the Agricultural Research Center (ARC), Giza, Egypt. Uniform seedlings were transplanted into pots (40 cm in diameter) contain a mixture of sand and clay (1:3 W/W), total 8 kg, in a plastic greenhouse at experimental plant garden of Botany and Microbiology Department, Faculty of Science, Al-Azhar University, Egypt. The pots were coordinated in a completely randomized design with 8 replicates for each treatment. Pots were arranged as follows; T1-Healthy control (sowing tomato seedlings in sterilized soil), T2-Infected control (sowing the tomato seedlings in sterilized soil inoculated with F. oxysporum), T3-Healthy plants treated with A. flavus, T4-Healthy plants treated with A. nidulans, T5-Healthy plants treated with A. fumigatus, T6-Healthy plants treated with combination of A. flavus, A. nidulas and A. fumigatus, T7-Infected plants treated with A. flavus and T8-Infected plants treated with A. nidulans, T9-Infected plants treated with A. fumigatus,T10-Infected plants treated with combination of A. flavus, A. nidulans and A. fumigatus. For plant resistance evaluation biochemical signals from plant samples were analyzed 45 days after sowing, and the disease was assayed.
Disease symptoms and disease index
The disease symptoms were observed 45 days after sowing and the disease index and plant protection were assessed using a score consisting of five classes, as described in Elbasuney et al. (2022) with minor modifications; (1) minor yellowing of lower leaves, (2) moderate yellow plant, (3) wilted plant with browning of vascular bands, and (4) severely stunted and damaged plants. The percent disease index (PDI) was determined using a five-grade scale and the formula: PDI = (1n1 + 2n2 + 3n3 + 4n4)100/4nt, where n1-n4 represents the number of plants in each class and nt represents the total number of plants examined. In addition, the following formula was used to obtain % Protection (P %): P % = (A–B/A) X100, where A is the PDI in infected control plants and B is the PDI in infected plants treated with fungal endophytes.
Photosynthetic pigment determination
A former procedure mentioned in the study Cohen-Bazire et al. (1966) was used to assess the existence of chlorophyll a (Chl a), chlorophyll b (Chl b) and carotenoids in fresh leaves. Throughout this technique, photosynthetic pigments were extracted from fresh leaves (0.5 g) using 50 mL of acetone (80%) then the green color was determined spectrophotometrically at 665, 649, and 470 nm after the extract was filtered.
Determination of the content of osmolytes
The soluble sugar content of the dried shoot was calculated by the method described by Irigoyen et al. (1992). The dried shoots (0.5 g) from each treatments were diluted with 5 mL of 30% trichloroacetic acid (TCA) and 2.5 mL of 2% phenol and filtered through filter paper, then 1 mL of the filtrate was treated with 2 mL of anthrone reagent (2 g anthrone/L of 95% H2SO4). 620 nm was used to determine the produced blue-green color.
The procedure of El-Tayeb (2005) was used to determine the soluble protein content of the dry shoot.One mL of this extract was combined with 5 mL of alkaline reagent (50 mL of 2% Na2CO3 prepared in 0.1 N NaOH and 1 mL of 0.5% CuSO4 prepared in 1% potassium sodium tartrate) and 0.5 mL of Folin’s reagent (diluted by 1:3 v/v). After 30 min, a color change could be seen at a wavelength of 750 nm.
The proline content was measured in the dry shoot according to Bates et al. (1973). The dried shoots (0.5 g) were digested by 10 mL (3%) of sulfosalicylic acid in this technique. Using a boiling water bath, 2 mL of the filtrate was mixed with 2 mL of ninhydrin acid and 2 mL of glacial acetic acid for an hour, then the mixture was placed in an ice bath to stop the reaction. 4 mL of toluene was added to the mixture, then the absorbance at 520 nm was determined.
Determination of total phenol contents
The technique of Jagota et al. (1982) was used to estimate the ascorbic acid content of the dry shoot. Total dry shoot phenol content was measured using the Dai et al. (1993) procedure.
Estimation of malondialdehyde and hydrogen peroxide contents
The content of MDA in fresh leaf was measured according to Hu et al. (2004). The H2O2 content of fresh leaf was measured as stated by Mukherjee and Choudhuri (1983).
Assay of antioxidant enzymes activity
POD activity was assayed according to that method described by Bergmeyer (1974). The activity of PPO was calculated by the procedure used by Matta and Dimond (1963). The activities of POD and PPO were assayed in fresh tomato leaves.
Isozymes electrophoresis
Native polyacrylamide gel electrophoresis (Native-PAGE) isozyme electrophoresis was performed to identify isozyme differences between control and treatment. PPO isozymes in leaves (100 mg fresh weight) samples were estimated as described by Bradford; Thipyapong, et al., (Bradford 1976; Thipyapong et al. 1995). POD in fresh leaves isozymes were assessed by the procedure defined by Barceló, et al. (1987).
Statistical analysis
One-way variance analysis (ANOVA) applied to the resulting data. The least significant difference (LSD test) using CoStat (CoHort, Monterey, CA, USA) was used to demonstrate statistically relevant differences between treatments at p < 0.05. Results are shown as mean ± standard errors (n = 3) according to Snedecor and Cochran (1980).
Results
Antifungal assayof endophytic fungi
Crude extracts of A. flavus MZ045563, A. fumigatus MZ045562 and A. nidulans MZ045561 were tested for antifungal activity against F. oxysporum. They inhibited the growth of F. oxysporum with inhibition zone diameters of 15.00, 12.33 and 20.83 mm respectively, whereas fluconazole had no impact (Table 1). Figure 1 illustrates some significant observations during the antifungal assay, both A. fumigatus and A. nidulans extracts had another impact further than the inhibition zones, such as absence of off white, fairly dense appearance of aerial mycelium with no production of light purple pigment in the diffusion zone of these extracts.
Overall, the results demonstrated that fungal extracts of A. flavus, A. fumigatus and A. nidulans displayed antifungal efficacy by reduction of the germination of F. oxysporum conidia in a concentration-dependent manner. When we compared different extract at the same times, the results were show (Fig. 2) difference between them but the extracts of A. nidulans (T-4) followed by A. flavus (T-7) showed a strong effect alternately at 24 and 48 h, while the effect of A. fumigatus (T-5) was always the lowest at these times, while after 72 h it was mostly reduced the germination of conidia than A. nidulans (T-4) followed by A. flavus (T-7). By comparing the concentrations of each extract at the same time, we observed substantial variations, and the concentration of 7.5 mg/mL exhibited most significant reduction of conidia germination, for example this concentration reduced the conidia germination by rate ranging from 94.40 to 100% after 24 h (Fig. 2).
Disease index
The results presented in the (Table 2) indicated that F. oxysporum highly destructive were the percentage of disease index (PDI) of infected tomato plants (84.37%). On the other hand, all tested endophytic isolates showed a great decrease in the disease symptoms and PDI and thus give a high percentage of protection (Table 2). Treatment of infected plants with combination of A. flavus, A. nidulance and A. fumigatus and A. nidulans were the best treatments which reduced percent disease indexes in (12.5% and 25%) as well as high protection by (85.18% and 70.36%) respectively then followed by A. fumigatus, and A. flavus which recorded PDI (34.37% and 37.50%) and protection (59.26% and 55.55%) respectively.
Photosynthetic pigments
The contents of chlorophyll a and b were highly significantly decreased in infected plants (Fig. 3). However infected plants treated with endophytic isolates (A. flavus, A. nidulans and A. fumigatus) individual or combination showed a significant increase when compared with infected plants. Furthermore, combination of A. flavus, A. nidulans and A. fumigatus then A. nidulans showed a significant increase in the contents of Chl a (83.68% and 81.06%) but combination of A. flavus, A. nidulans and A. fumigatus then A. flavus resulted to a significant increase in Chl b by (93.67% and 81.10%) respectively. The healthy tomato plants treated with with endophytic isolates (A. flavus, A. nidulans and A. fumigatus) singular or mixture showed a significant increase in chlorophyll a and b. On the other hand, in infected plants the content of carotenoids decreased by 42.02% when being compared with healthy plants. Moreover, the obtained results illustrated that in Fusarium infected plants the content of carotenoids was increased in response to the treatment with endophytic isolates (A. flavus, A. nidulans and A. fumigatus) individual or combination.
Effect of F. oxysporum and endophytic isolates (A. flavus, A. nidulans and A. fumigatus) individual or combination on photosynthetic pigments of tomato plants. Data presented as means ± SD (n = 3). Data followed by different letters (a:f) are significantly different LSD test at P ≤ 0.05. FW: fresh weight. ( T1-Healthy control; T2-Infected control; T3-Healthy treated with A. flavus; T4-Healthy treated with A. nidulance; T5-Healthy treated with A. fumigatus; T6-Healthy treated with combination of A. flavus, A. nidulance and A. fumigatus; T7-Infected treated with A. flavus; T8-Infected treated with A. nidulance; T9-Infected treated with A. fumigatus and T10-Infected treated with combination of A. flavus, A. nidulance and A. fumigatus
Osmolytes
Fusarium infected tomato plants showed decrease in contents of soluble charbohydrates and soluble proteins by 53.82% and 46.43% respectively (Fig. 4). On the other hand, the content of proline and phenols were increased significantly by 75.39% and 72.30% as compared to healthy control plants. Application of endophytic isolates (A. flavus, A. nidulans and A. fumigatus) enhanced the contents of soluble charbohydrates, soluble proteins, prolin and phenols in shoots of infected tomato plants compred to infected control. The highest recorded increase in contents of soluble sugars, soluble proteins, proline and protein content was noticed in combination of A. flavus, A. nidulans and A. fumigatus by 92.015%, 77.85%, 26.78% and 45.90% respectively over Fusarium infected plants. Application of endophytic isolates A. flavus, A. nidulans and A. fumigatus individual or combination on healthy plants elevated the contents of soluble charbohydrates, soluble proteins, prolin content and phenols respectively over healthy control plants (Fig. 4). The highest recorded increase in response to application of tested endophytic isolates on healthy plants were in the case of Combination of A. flavus, A. nidulans and A. fumigatus.
Effect of F. oxysporum and endophytic isolates on osmolytes (mg/g dry weight) of tomato plants. Data presented as means ± SD (n = 3). Data followed by different letters (a:f) are significantly different LSD test at P ≤ 0.05. FW: fresh weight. (T1-Healthy control; T2-Infected control; T3-Healthy treated with A. flavus; T4-Healthy treated with A. nidulance; T5-Healthy treated with A. fumigatus; T6-Healthy treated with combination of A. flavus, A. nidulance and A. fumigatus; T7-Infected treated with A. flavus;T8-Infected treated with A. nidulance; T9-Infected treated with A. fumigatus and T10-Infected treated with combination of A. flavus, A. nidulance and A. fumigatus)
Oxidative stress
Fusarium infection caused accumulation the contents of MDA and H2O2 by 48.86% and 95.99% respectively, comparing to healthy tomato plants (Fig. 5). The content of MDA was dropped in response to different endophytic isolates treatments by 31.53%, 29.86%, 26.23%, and 23.25% at combination of A. flavus, A. nidulans and A. fumigatus, A. flavus, A. nidulance and A. fumigatus respectively. The application of endophytes singular or mixure decreased the MDA of healthy tomato plant. While the content of H2O2 was decreased by 39.24%, 33.47%, 26.65%, 6.57% at combination of A. flavus, A. nidulans and A. fumigatus, A. nidulans, A. fumigatus, and A. flavus, respectively comparing to infected control (Fig. 5). The application of endophytes odd or mixure increased the H2O2 of healthy tomato plant. The highest value of H2O2 recorded by A. flavus. The activity of POD and PPO were boosted in Fusarium infected tomato plants comparing to healthy (Fig. 5). Moreover, application of all tested endophytic isolates were increased the activity of POD and PPO. The highest recorded increase in POD and PPO activity in response to application of tested endophytic isolates on infected plants was in the case of Combination of A. flavus, A. nidulans and A. fumigatus. On the other hand, application of endophytes increased the POD and PPO activities of healthy tomato plants. The most effective treatment was combination of A. flavus, A. nidulans and A. fumigatus.
Effect of F. oxysporum and endophytic isolates on (MDA) (nmol g−1 fresh weight); (H2O2) (mg g−1 fresh weight); POD (unit/g) f. wt./h. and PPO(unit/g) f. wt./ h. of tomato plants. Data presented as means ± SD (n = 3). Data followed by different letters are significantly different LSD test at P ≤ 0.05. (T1-Healthy control; T2-Infected control; T3-Healthy treated with A. flavus; T4-Healthy treated with A. nidulance; T5-Healthy treated with A. fumigatus; T6-Healthy treated with combination of A. flavus, A. nidulance and A. fumigatus; T7-Infected treated with A. flavus; T8-Infected treated with A. nidulance; T9-Infected treated with A. fumigatus and T10-Infected treated with combination of A. flavus, A. nidulance and A. fumigatus)
Isozymes
Peroxidase (POD) isozymes
Native PAGE in (Fig. 6) and (Table 3) appered five POD isozymes at Rf (0.378, 0.568, 0.795, 0.849 and 0.908). Fusarium-infected plants showed greatly overexpressed POD that showed 5 bands including one faint band, three moderate bands and one highly dense band. Control healthy plants expressed the lowest POD expression that they produced 3 faint bands and tow moderate band. The highest recorded increase in POD expressed in response to application of tested endophytic isolates on infected plants was in the case of combination of A. flavus, A. nidulans and A. fumigatus; A. fumigatus; A. flavus and finally A. nidulans respectively.
Effect of F. oxysporum and endophytic isolates on peroxidase isozyme of tomato plants. A POD, B Ideogram analysis of POD isozyme (T1-Healthy control; T2-Infected control; T3-Healthy treated with A. flavus; T4-Healthy treated with A. nidulance; T5-Healthy treated with A. fumigatus; T6-Healthy treated with combination of A. flavus, A. nidulance and A. fumigatus; T7-Infected treated with A. flavus; T8-Infected treated with A. nidulance; T9-Infected treated with A. fumigatus and T10-Infected treated with combination of A. flavus, A. nidulance and A. fumigatus)
Polyphenoloxidase (PPO) isozymes
The polyphenol oxidase isozyme of tomato plant leaves showed five PPO isozymes at Rf (0.391, 0.528, 0.724, 0.809 and 0.876) (Fig. 7) and (Table 4).Untreated Infected plants showed the highly PPO expression that produced 4 bands including three moderate bands and one faint band when compared with Untreated control healthy plants that expressed the lowest PPO that produced 3 faint bands. Under Fusarium infection conditions it was found that the the highest recorded increase in PPO expressed in response to application of tested endophytic isolates on infected plants was in the case of combination of A. flavus, A. nidulance and A. fumigatus then A. flavus, A. nidulance and finally A. fumigatus respectively.
Effect of F. oxysporum and endophytic isolates on PPO isozyme of tomato plants. A PPO, B Ideogram analysis of PPO isozyme (T1-Healthy control; T2-Infected control; T3-Healthy treated with A. flavus; T4-Healthy treated with A. nidulance; T5-Healthy treated with A. fumigatus; T6-Healthy treated with combination of A. flavus, A. nidulance and A. fumigatus; T7-Infected treated with A. flavus; T8-Infected treated with A. nidulance; T9-Infected treated with A. fumigatus and T10-Infected treated with combination of A. flavus, A. nidulance and A. fumigatus)
Discussion
Fusarium wilt disease is considered one of the greatest serious challenges facing countries, especially Egypt. Crops are being destroyed all over the world, including Egypt by soil-borne diseases such as F. oxysporum that cause great losses in terms of quantity and quality (Abdelaziz et al. 2021; Attia et al. 2021a, b). Therefore, the study of environmental influences and pathogenic factors that are increasing in severity makes it important to search for safe and easy-to-use alternatives with high efficiency against plant pathogens (Adnan et al. 2019; Chen 2020). F. oxysporum produces mycelia, conidia, and chlamydospores that play a role during host infection, producing damaging vascular wilts, rots and damping-off diseases (Doohan and Zhou 2017; Srinivas et al. 2019). However, in this study, endophytic fungal extracts had the ability to inhibit F. oxysporum growth as well as the formation of both aerial hyphae and pigmentation outside of the inhibitory zones. Furthermore, these extracts greatly reduced the germination of F. oxysporum conidia. The crude extracts of endophytic fungi under investigation include antifungal compounds such as 9-Octadecenoic acid (Z) methyl ester, methyl stearate, 9,17-Octadecadienal (Z) Linoleoyl chloride, and ethyl iso-allocoholate (Sharaf et al. 2022). Endophytic aspergilli were applied as smart biological control against Fusarium wilt as well as induction of healthy tomato plants by enhancement the systemic resistance of the tomato plant against Fusarium wilt disease. Tomato plants treated with endophytic aspergilli showed improvement of the morphological, physiological, molecular traits of infected tomato plants (Dhouib et al. 2019; Abdel-Motaal et al. 2020; Aldinary et al. 2021).
Disease severity was the first guide to govern systemic resistance in treated plants by endophytic fungi. Results presented in this study reported that F. oxysporum shows a highly destructive effect on tomato plants that caused typical wilt symptoms with DI 84.37%, which is similar to earlier studies on the same pathogenic fungus (Sathiyabama and Charles 2015; Abdallah et al. 2016; Srinivas et al. 2019; Abdelaziz et al. 2022c). Using endophytic fungi extracts to treat Fusarium wilt-infected tomato plants greatly reduced the disease symptoms, which is the primary criterion for assessing resistance in the tomato plant. Results showed that treatment of infected plants with combination of A. flavus, A. nidulans and A. fumigatus and A. nidulans were the best treatments which reduced percent disease indexes by (12.5% and 25%) and increased protection by (85.18 and 70.36%) respectively then A. fumigatus and A. flavus which recorded PDI by (34.37% and 37.50%) and protection by (59.26% and 55.55%) respectively, these results are consistent with (Alabouvette et al. 2009; Righini and Roberti 2019).
Vegetative growth (shoot length, root length and number leaves per plant) were significantly decreased due to F. oxysporum. It should be noted that, the destruction of vegetative growth traits may be related to various factors; Among them are hormonal disruption, oxidative explosion, pathogen control over cell contents, and consequently high osmotic pressure (Sagi et al. 2004; Bashan and De-Bashan 2010; Kang et al. 2021). Many studies have shown that the application of endophytic fungi such as A. alabamensis, A. tubingensis and A. oryzae improved tomato morphological traits (Nefzi et al. 2019, Aldinary et al. 2021) and biostimulate tolerance of seedlings under biotic stress conditions as well as healthy plants (Khan et al. 2012; Morsy et al. 2020; Saia et al. 2021; Sonawane et al. 2022).
The improvement of the photosynthesis pigments is a strong positive evidence for the occurrence of resistance against the disease as a result of the application of endophytic fungi extracts and became one of the visible evidence. In the present study the contents of chlorophyll a and b were highly significantly decreased in infected tomato plants due to Fusarium infection. The severe deficiency of chlorophyll pigments may be due to a decrease in the number of leaves responsible for light capture and photosynthesis, or it may also be due to increased activities of chlorophyll-degrading enzymes (Hörtensteiner and Kräutler 2011; Rahman 2019). Results of the current study showed that treatment of infected tomato plants by endophytic fungi extracts significantly improved plant resistance by increasing photosynthetic pigments. This increase might be approved to enhanced stomatal conductance, transpiration rate and/or cell size and number (Maghsoudi et al. 2016; Ferus et al. 2019). Endophytic fungi may confer additional plant defensive mechanisms as jasmonic acid, or salicylic acid (Ownley et al. 2010; Yan et al. 2019; Poveda et al. 2020). Also it may trigger NADPH oxidase activity, thereby activating the production of H2O2 or by the antioxidant activity,thus, endophytic fungi could activate ROS scavenging systems in plants (Zou et al. 2021). The accumulation of osmolyte plays a vital role in capturing free radicals, protecting cells from oxidation, and supplying plant cells with energy (Szabados and Savouré 2010; Das and Roychoudhury 2014). Application of endophytic fungi extracts especially combination of A. flavus, A. nidulans and A. fumigatus enhanced osmolytes in shoots of tomato plants. These results are in agreement with study achieved by Aldinary et al. (2021). Endophytic fungi caused an enhancement in the contents of soluble sugars, soluble protein throughout its role in increasing the expression of enzymes involved in glycolysis (Ghaffari et al. 2019; De Rocchis et al. 2022). The accumulation of proline in the plant prevents the damage of the photosynthesis pigments by capturing the free radicals (Alnusairi et al. 2021). In this study, Fusarium infection increased the contents of total phenols in tomato plants. Our results are in harmony with other researchers (Baaziz 2011; Mikulic-Petkovsek et al. 2013; Abdelaziz et al. 2021). Phenols play an important role in capturing free radicals which reduces oxidative stress in cells (Murray et al. 2007). The accumulation of phenolic compounds serves as an adaptive strategy against plant disease (Daayf et al. 2012). Our study indicated that treatment with A. flavus, A. fumigatus and A. nidulans improved contents of phenolic compounds significantly which directly decay lipid oxidation during transporting a phenolic hydrogen atom to a radicle (Kim et al. 2007; Ćilerdžić et al. 2014). Oxidative stress caused by F. oxysporum led to serious disruption of plant cell and increase the contents of MDA and H2O2 in leaves of tomato plants. The content of MDA and H2O2 were dropped in response to different endophytic isolates treatments.
Moreover, Khan et al. (2012) stated that endophyte application significantly reduced the contents of MDA in stressed plants. Abdelaziz et al. (2021) reported that antioxidant enzymes POD and PPO provide a large number of defensive enzymes associated with Fusarium infection. These enzymes act as initial steps in increasing plant resistance to various stresses (Van Loon et al. 1998; Rios-Gonzalez et al. 2002). The results showed that the activity of POD and PPO were boosted in Fusarium infected tomato plants comparing to untreated control plants. Moreover, application of all tested endophytic isolates (A. flavus, A. nidulans and A. fumigatus) individual or combination resulted to increasing the activity of POD and PPO as compared with control. The plants showed different mechanisms to adaptive with stress by increase the activity of certain antioxidant enzymes to keep ROS at the lower level in the cell. POD plays an important role in elimination of H2O2 excess by bioconversion to H2O (Rios-Gonzalez et al. 2002). POD and PPO activities increased in infected plants as well as plants treated with tested endophytic isolates (A. flavus, A. nidulans and A. fumigatus) compared to un-treated infected plants. Isozymes are one of the key control mechanisms for cell metabolism in plants, thus changes in isozyme profiles play an important role in cellular protection against pathogens (Harb et al. 2010, Shigeoka et al. 2022). The induction of isozymes play an important role in the cellular defense against oxidative stress (El-Beltagi et al. 2010). These results reflecting the ameliorative role of endophytic isolates (A. flavus, A. nidulans and A. fumigatus) in protecting tomato plants against Fusarium wilt in tomato plant.
Conclusions
Application of ethyl acetate extracts of (A. flavus, A. nidulans and A. fumigatus) ameliorate the negative impact of tomato Fusarium wilt through reduced PDI and enhancement of protection against pathothogen, improvement photosynthetic pigments, increasing osmoprotectant compounds and antioxidant system. So it could be used in agricultural fields especially combination of A. flavus, A. nidulans and A. fumigatus. For more, Application of A. flavus, A. nidulans and A. fumigatus singalular or combination to enhancement healthy tomato plant growth. Ethyl acetate extracts of A. flavus, A. nidulance and A. fumigatus can be applied as safe biofungicide as well as biostimulant of growth. Accordingly, endophytic fungi (A. flavus, A. nidulans and A. fumigatus) are promising isolates for potential applications in agricultural application and as smart biological control against F. oxysporum which infected tomato plants and causing wilt disease. In the future, these isolates should be highlighted and applied as biocides and therapeutic nutrients to reduce the spread of plant diseases and improve plant immunity).
Availability of data and materials
All data and materials viable.
References
Abdallah RAB, Mokni-Tlili S, Nefzi A, Jabnoun-Khiareddine H, Daami-Remadi M (2016) Biocontrol of Fusarium wilt and growth promotion of tomato plants using endophytic bacteria isolated from Nicotiana glauca organs. Biol Control 97:80–88. https://doi.org/10.1016/j.biocontrol.2016.03.005
Abdelaziz AM, Dacrory S, Hashem AH, Attia MS, Hasanin M, Fouda HM, Kamel S, ElSaied H (2021) Protective role of zinc oxide nanoparticles based hydrogel against wilt disease of pepper plant. Biocatal Agric Biotechnol 35:102083. https://doi.org/10.1016/j.bcab.2021.102083
Abdelaziz AM, Attia MS, Salem MS, Refaay DA, Alhoqail WA, Senousy HH (2022a) Cyanobacteria-mediated immune responses in pepper plants against Fusarium wilt. Plants. https://doi.org/10.3390/plants11152049
Abdelaziz AM, El-Wakil DA, Attia MS, Ali OM, AbdElgawad H, Hashem AH (2022b) Inhibition of Aspergillus flavus growth and aflatoxin production in Zea mays L. using endophytic Aspergillus fumigatus. J Fungi 8(5):482. https://doi.org/10.3390/jof8050482
Abdelaziz AM, Salem SS, Khalil A, El-Wakil DA, Fouda HM, Hashem AH (2022c) Potential of biosynthesized zinc oxide nanoparticles to control Fusarium wilt disease in eggplant (Solanum melongena) and promote plant growth. Biometals 35:601–616. https://doi.org/10.1007/s10534-022-00391-8
Abdel-Motaal F, Kamel N, El-Zayat S, Abou-Ellail M (2020) Early blight suppression and plant growth promotion potential of the endophyte Aspergillus flavus in tomato plant. Ann Agric Sci 65(2):117–123. https://doi.org/10.1016/j.aoas.2020.07.001
Adnan M, Islam W, Shabbir A, Khan KA, Ghramh HA, Huang Z, Chen HY, Lu G-D (2019) Plant defense against fungal pathogens by antagonistic fungi with Trichoderma in focus. Microb Pathog 129:7–18. https://doi.org/10.1016/j.micpath.2019.01.042
Alabouvette C, Olivain C, Migheli Q, Steinberg C (2009) Microbiological control of soil-borne phytopathogenic fungi with special emphasis on wilt-inducing Fusarium oxysporum. New Phytol 184(3):529–544. https://doi.org/10.1111/j.1469-8137.2009.03014.x
Aldinary AM, Abdelaziz AM, Farrag AA, Attia MS (2021) Biocontrol of tomato Fusarium wilt disease by a new Moringa endophytic Aspergillus isolates. Mater Today Proc. https://doi.org/10.1016/j.matpr.2021.03.423
Alnusairi GS, Mazrou YS, Qari SH, Elkelish AA, Soliman MH, Eweis M, ElNahhas N (2021) Exogenous nitric oxide reinforces photosynthetic efficiency, osmolyte, mineral uptake, antioxidant, expression of stress-responsive genes and ameliorates the effects of salinity stress in wheat. Plants 10(8):1693. https://doi.org/10.3390/plants10081693
Attia MS, El-Naggar HA, Abdel-Daim MM, El-Sayyad GS (2021a) The potential impact of Octopus cyanea extracts to improve eggplant resistance against Fusarium-wilt disease: in vivo and in vitro studies. Environ Sci Pollut Res 28(27):35854–35869. https://doi.org/10.1007/s11356-021-13222-z
Attia MS, El-Sayyad GS, Abd Elkodous M, Khalil WF, Nofel MM, Abdelaziz AM, Farghali AA, El-Batal AI, El Rouby WM (2021b) Chitosan and EDTA conjugated graphene oxide antinematodes in Eggplant: toward improving plant immune response. Int J Biol Macromol 179:333–344. https://doi.org/10.1016/j.ijbiomac.2021.03.005
Attia MS, Abdelaziz AM, Al-Askar AA, Arishi AA, Abdelhakim AM, Hashem AH (2022a) Plant growth-promoting fungi as biocontrol tool against Fusarium wilt disease of tomato plant. J Fungi 8(8):775. https://doi.org/10.3390/jof8080775
Attia MS, El-Wakil DA, Hashem AH, Abdelaziz AM (2022b) Antagonistic effect of plant growth-promoting fungi against Fusarium wilt disease in tomato: in vitro and in vivo study. Appl Biochem Biotechnol 194:5100–5118. https://doi.org/10.1007/s12010-022-03975-9
Attia MS, Hashem AH, Badawy AA, Abdelaziz AM (2022c) Biocontrol of early blight disease of eggplant using endophytic Aspergillus terreus: improving plant immunological, physiological and antifungal activities. Bot Stud 63(1):1–14. https://doi.org/10.1186/s40529-022-00357-6
Baaziz M (2011) Arbuscular mycorrhizal fungi limit incidence of Fusarium oxysporum f. sp. albedinis on date palm seedlings by increasing nutrient contents, total phenols and peroxidase activities. Open Hortic J. https://doi.org/10.2174/1874840601104010010
Badawy AA, Alotaibi MO, Abdelaziz AM, Osman MS, Khalil AM, Saleh AM, Mohammed AE, Hashem AH (2021) Enhancement of seawater stress tolerance in barley by the endophytic fungus Aspergillus ochraceus. Metabolites 11(7):428
Barceló AR, Muñoz R, Sabater F (1987) Lupin peroxidases. I. Isolation and characterization of cell wall-bound isoperoxidase activity. Physiol Plant 71(4):448–454. https://doi.org/10.1111/j.1399-3054.1987.tb02882.x
Bashan Y, De-Bashan LE (2010) How the plant growth-promoting bacterium Azospirillum promotes plant growth—a critical assessment. Adv Agron 108:77–136. https://doi.org/10.1016/S0065-2113(10)08002-8
Bates LS, Waldren RP, Teare I (1973) Rapid determination of free proline for water-stress studies. Plant Soil 39(1):205–207. https://doi.org/10.1007/BF00018060
Bergmeyer H (1974) Determination with glucose oxidase and peroxidase. Methods Enzym Anal. https://doi.org/10.1007/BF00018060
Bradford MM (1976) A rapid and sensitive method for the quantitation of microgram quantities of protein utilizing the principle of protein-dye binding. Anal Biochem 72(1–2):248–254. https://doi.org/10.1006/abio.1999.4298
Büttner G, Pfähler B, Märländer B (2004) Greenhouse and field techniques for testing sugar beet for resistance to Rhizoctonia root and crown rot. Plant Breed 123(2):158–166. https://doi.org/10.1046/j.1439-0523.2003.00967.x
Chakraborty U, Chakraborty B, Basnet M (2006) Plant growth promotion and induction of resistance in Camellia sinensis by Bacillus megaterium. J Basic Microbiol 46(3):186–195. https://doi.org/10.1002/jobm.200510050
Chen X (2020) Pathogens which threaten food security: Puccinia striiformis, the wheat stripe rust pathogen. Food Security 12(2):239–251. https://doi.org/10.1007/s12571-020-01016-z
Christ B, Hörtensteiner S (2014) Mechanism and significance of chlorophyll breakdown. J Plant Growth Regul 33(1):4–20. https://doi.org/10.1007/s00344-013-9392-y
Ćilerdžić J, Vukojević J, Stajić M, Stanojković T, Glamočlija J (2014) Biological activity of Ganoderma lucidum basidiocarps cultivated on alternative and commercial substrate. J Ethnopharmacol 155(1):312–319. https://doi.org/10.1016/j.jep.2014.05.036
Cohen-Bazire G, Sistrom W, Vernon L, Seeley G (1966) The Chlorophylls. Academic Press, New York
Daayf F, El Hadrami A, El-Bebany AF, Henriquez MA, Yao Z, Derksen H, El Hadrami I, Adam LR (2012) Phenolic compounds in plant defense and pathogen counter-defense mechanisms. Recent Adv Polyphen Res 3(3):191–208. https://doi.org/10.1002/9781118299753.ch8
Dai, G. H., Andary, C., Cosson-Mondolot, L., & Boubals, D. (1993, September). Polyphenols and resistance of grapevines to downy mildew. In International Symposium on Natural Phenols in Plant Resistance 381 (pp. 763-766). https://doi.org/10.17660/ActaHortic.1994.381.110
Das K, Roychoudhury A (2014) Reactive oxygen species (ROS) and response of antioxidants as ROS-scavengers during environmental stress in plants. Front Environ Sci 2:53. https://doi.org/10.3389/fenvs.2014.00053
De Rocchis V, Jammer A, Camehl I, Franken P, Roitsch T (2022) Tomato growth promotion by the fungal endophytes Serendipita indica and Serendipita herbamans is associated with sucrose de-novo synthesis in roots and differential local and systemic effects on carbohydrate metabolisms and gene expression. J Plant Physiol 276:153755. https://doi.org/10.1016/j.jplph.2022.153755
Dhouib H, Zouari I, Abdallah DB, Belbahri L, Taktak W, Triki MA, Tounsi S (2019) Potential of a novel endophytic Bacillus velezensis in tomato growth promotion and protection against Verticillium wilt disease. Biol Control 139:104092. https://doi.org/10.1016/j.biocontrol.2019.104092
Doohan F, Zhou B (2017) Fungal pathogens of plants. In: Kavanagh K (ed) Fungi: biology and applications. John Wiley & Sons Inc, Hoboken, pp 355–387. https://doi.org/10.1002/9781119374312.ch14
Elbasuney S, El-Sayyad GS, Attia MS, Abdelaziz AM (2022) Ferric oxide colloid: towards green nano-fertilizer for tomato plant with enhanced vegetative growth and immune response against Fusarium wilt disease. J Inorg Organomet Polym Mater. https://doi.org/10.1007/s10904-022-02442-6
El-Beltagi HS, Mohamed AA, Rashed MM (2010) Response of antioxidative enzymes to cadmium stress in leaves and roots of radish (Raphanus sativus L/). Not Sci Biol 2(4):76–82. https://doi.org/10.15835/nsb245395
Elghaffar RYA, Amin BH, Hashem AH, Sehim AE (2022) Promising endophytic Alternaria alternata from leaves of Ziziphus spina-christi: phytochemical analyses, antimicrobial and antioxidant activities. Appl Biochem Biotechnol 194(9):3984–4001. https://doi.org/10.1007/s12010-022-03959-9
Elmholt S (1996) Microbial activity, fungal abundance, and distribution of Penicillium and Fusarium as bioindicators of a temporal development of organically cultivated soils. Biol Agric Hortic 13(2):123–140. https://doi.org/10.1080/01448765.1996.9754772
El-Tayeb MA (2005) Response of barley grains to the interactive effect of salinity and salicylic acid. Plant Growth Regul 45(3):215–224. https://doi.org/10.1007/s10725-005-4928-1
Ferus P, Barta M, Konôpková J (2019) Endophytic fungus Beauveria bassiana can enhance drought tolerance in red oak seedlings. Trees 33(4):1179–1186. https://doi.org/10.1007/s00468-019-01854-1
Ghaffari MR, Mirzaei M, Ghabooli M, Khatabi B, Wu Y, Zabet-Moghaddam M, Mohammadi-Nejad G, Haynes PA, Hajirezaei MR, Sepehri M (2019) Root endophytic fungus Piriformospora indica improves drought stress adaptation in barley by metabolic and proteomic reprogramming. Environ Exp Bot 157:197–210. https://doi.org/10.1016/j.envexpbot.2018.10.002
Harb A, Krishnan A, Ambavaram MM, Pereira A (2010) Molecular and physiological analysis of drought stress in Arabidopsis reveals early responses leading to acclimation in plant growth. Plant Physiol 154(3):1254–1271. https://doi.org/10.1104/pp.110.161752
Hashem AH, Abdelaziz AM, Askar AA, Fouda HM, Khalil AM, Abd-Elsalam KA, Khaleil MM (2021) Bacillus megaterium-mediated synthesis of selenium nanoparticles and their antifungal activity against Rhizoctonia solani in Faba Bean Plants. Journal of Fungi 7(3):195. https://doi.org/10.3390/jof7030195
Hashem AH, Shehabeldine AM, Abdelaziz AM, Amin BH, Sharaf MH (2022) Antifungal activity of endophytic Aspergillus terreus extract against some fungi causing mucormycosis: ultrastructural study. Appl Biochem Biotechnol. https://doi.org/10.1007/s12010-022-03876-x
Hibar K, Edel-Herman V, Steinberg C, Gautheron N, Daami-Remadi M, Alabouvette C, El Mahjoub M (2007) Genetic diversity of Fusarium oxysporum populations isolated from tomato plants in Tunisia. J Phytopathol 155(3):136–142. https://doi.org/10.1111/j.1439-0434.2007.01198.x
Hörtensteiner S, Kräutler B (2011) Chlorophyll breakdown in higher plants. Biochim et Biophys Acta BBA Bioenerg 1807(8):977–988. https://doi.org/10.1016/j.bbabio.2010.12.007
Hu Z, Richter H, Sparovek G, Schnug E (2004) Physiological and biochemical effects of rare earth elements on plants and their agricultural significance: a review. J Plant Nutr 27(1):183–220. https://doi.org/10.1081/PLN-120027555
Hyakumachi M (2013) Research on biological control of plant diseases: present state and perspectives. J Gen Plant Pathol 79(6):435–440. https://doi.org/10.1007/s10327-013-0484-0
Irigoyen J, Einerich D, Sánchez-Díaz M (1992) Water stress induced changes in concentrations of proline and total soluble sugars in nodulated alfalfa (Medicago sativd) plants. Physiol Plant 84(1):55–60
Jackson AO, Taylor CB (1996) Plant-microbe interactions: life and death at the interface. Plant Cell 8(10):1651. https://doi.org/10.1111/j.1399-3054.1992.tb08764.x
Jagota S, Dani H (1982) A new colorimetric technique for the estimation of vitamin C using Folin phenol reagent. Anal Biochem 127(1):178–182. https://doi.org/10.1016/0003-2697(82)90162-2
Kang SG, Lee KE, Singh M, Kumar P, Matin MN (2021) Rice lesion mimic mutants (LMM): the current understanding of genetic mutations in the failure of ROS scavenging during lesion formation. Plants 10(8):1598. https://doi.org/10.3390/plants10081598
Khalil AMA, Hashem AH, Abdelaziz AM (2019) Occurrence of toxigenic Penicillium polonicum in retail green table olives from the Saudi Arabia market. Biocatal Agric Biotechnol 21:101314. https://doi.org/10.1016/j.bcab.2019.101314
Khalil A, Abdelaziz A, Khaleil M, Hashem A (2021) Fungal endophytes from leaves of Avicennia marina growing in semi-arid environment as a promising source for bioactive compounds. Lett Appl Microbiol 72(3):263–274. https://doi.org/10.1111/lam.13414
Khan AL, Hamayun M, Kang SM, Kim YH, Jung HY, Lee JH, Lee IJ (2012) Endophytic fungal association via gibberellins and indole acetic acid can improve plant growth under abiotic stress: an example of Paecilomyces formosus LHL10. BMC Microbiol 12(1):1–14. https://doi.org/10.1186/1471-2180-12-3
Khattab AM, Abo-Taleb HA, Abdelaziz AM, El-Tabakh MA, El-Feky MM, Abu-Elghait M (2022) Daphnia magna and Gammarus pulex, novel promising agents for biomedical and agricultural applications. Sci Rep 12(1):1–9. https://doi.org/10.1038/s41598-022-17790-z
Kim J, Campbell B, Mahoney N, Chan K, Molyneux R, May G (2007) Enhanced activity of strobilurin and fludioxonil by using berberine and phenolic compounds to target fungal antioxidative stress response. Lett Appl Microbiol 45(2):134–141. https://doi.org/10.1111/j.1472-765X.2007.02159.x
Maghsoudi K, Emam Y, Pessarakli M (2016) Effect of silicon on photosynthetic gas exchange, photosynthetic pigments, cell membrane stability and relative water content of different wheat cultivars under drought stress conditions. J Plant Nutr 39(7):1001–1015. https://doi.org/10.1080/01904167.2015.1109108
Matta A, Dimond AE (1963) Symptoms of Fusarium wilt in relation to quantity of fungus and enzyme activity in tomato stems. Phytopathology 53(5):574. https://doi.org/10.1016/B978-0-12-675402-5.50009-X
Mikulic-Petkovsek M, Schmitzer V, Jakopic J, Cunja V, Veberic R, Munda A, Stampar F (2013) Phenolic compounds as defence response of pepper fruits to Colletotrichum coccodes. Physiol Mol Plant Pathol 84:138–145. https://doi.org/10.1016/j.pmpp.2013.09.003
Morsy M, Cleckler B, Armuelles-Millican H (2020) Fungal endophytes promote tomato growth and enhance drought and salt tolerance. Plants 9(7):877. https://doi.org/10.3390/plants9070877
Mukherjee S, Choudhuri M (1983) Implications of water stress-induced changes in the levels of endogenous ascorbic acid and hydrogen peroxide in Vigna seedlings. Physiol Plant 58(2):166–170. https://doi.org/10.1111/j.1399-3054.1983.tb04162.x
Murray A, Kisin E, Castranova V, Kommineni C, Gunther M, Shvedova A (2007) Phenol-induced in vivo oxidative stress in skin: evidence for enhanced free radical generation, thiol oxidation, and antioxidant depletion. Chem Res Toxicol 20(12):1769–1777. https://doi.org/10.1021/tx700201z
Nefzi A, Abdallah RAB, Jabnoun-Khiareddine H, Ammar N, Daami-Remadi M (2019) Ability of endophytic fungi associated with Withania somnifera L. to control Fusarium Crown and Root Rot and to promote growth in tomato. Braz J Microbiol 50(2):481–494. https://doi.org/10.1007/s42770-019-00062-w
Nisa H, Kamili AN, Nawchoo IA, Shafi S, Shameem N, Bandh SA (2015) Fungal endophytes as prolific source of phytochemicals and other bioactive natural products: a review. Microb Pathog 82:50–59. https://doi.org/10.1016/j.micpath.2015.04.001
Olatunji TL, Afolayan AJ (2018) The suitability of chili pepper (Capsicum annuum L.) for alleviating human micronutrient dietary deficiencies: a review. Food Sci Nutr 6(8):2239–2251. https://doi.org/10.1002/fsn3.790
Ownley BH, Gwinn KD, Vega FE (2010) Endophytic fungal entomopathogens with activity against plant pathogens: ecology and evolution. Biocontrol 55(1):113–128. https://doi.org/10.1007/s10526-009-9241-x
Poveda J, Abril-Urias P, Escobar C (2020) "Biological control of plant-parasitic nematodes by filamentous fungi inducers of resistance: trichoderma, mycorrhizal and endophytic fungi. Front Microbiol 11:992. https://doi.org/10.3389/fmicb.2020.00992
Rahman MA (2019) Rice (Oryza sativa) receptor for activated C kinase1b (OsRACK1B) regulates chlorophyll catabolism oxidative stress signaling and pollen development pathways. FASEB J. https://doi.org/10.1096/fasebj.2020.34.s1.06651
Righini H, Roberti R (2019) Algae and cyanobacteria as biocontrol agents of fungal plant pathogens. In: Varma A, Tripathi S, Prasad R (eds) Plant microbe interface. Springer, Berlin, pp 219–238. https://doi.org/10.1017/S0021859621000885
Rios-Gonzalez K, Erdei L, Lips SH (2002) The activity of antioxidant enzymes in maize and sunflower seedlings as affected by salinity and different nitrogen sources. Plant Sci 162(6):923–930. https://doi.org/10.1016/S0168-9452(02)00040-7
Rongai D, Milano F, Sciò E (2012) Inhibitory effect of plant extracts on conidial germination of the phytopathogenic fungus Fusarium oxysporum. Am J Plant Sci. https://doi.org/10.4236/ajps.2012.312207
Sagi M, Davydov O, Orazova S, Yesbergenova Z, Ophir R, Stratmann JW, Fluhr R (2004) Plant respiratory burst oxidase homologs impinge on wound responsiveness and development in Lycopersicon esculentum. Plant Cell 16(3):616–628. https://doi.org/10.1105/tpc.019398
Saia S, Corrado G, Vitaglione P, Colla G, Bonini P, Giordano M, Stasio ED, Raimondi G, Sacchi R, Rouphael Y (2021) An endophytic fungi-based biostimulant modulates volatile and non-volatile secondary metabolites and yield of greenhouse basil (Ocimum basilicum L.) through variable mechanisms dependent on salinity stress level. Pathogens 10(7):797. https://doi.org/10.3390/pathogens10070797
Sathiyabama M, Charles RE (2015) Fungal cell wall polymer based nanoparticles in protection of tomato plants from wilt disease caused by Fusarium oxysporum f. sp. lycopersici. Carbohyd Polym 133:400–407. https://doi.org/10.1016/j.carbpol.2015.07.066
Sharaf MH, Abdelaziz AM, Kalaba MH, Radwan AA, Hashem AH (2022) Antimicrobial, antioxidant, cytotoxic activities and phytochemical analysis of fungal endophytes isolated from Ocimum basilicum. Appl Biochem Biotechnol 194(3):1271–1289. https://doi.org/10.1007/s12010-021-03702-w
Shigeoka S, Ishikawa T, Tamoi M, Miyagawa Y, Takeda T, Yabuta Y, Yoshimura K (2002) Regulation and function of ascorbate peroxidase isoenzymes. J Exp Bot 53(372):1305–1319. https://doi.org/10.1093/jexbot/53.372.1305
Snedecor G, Cochran WG (1980) Statistical methods. Iowa State University, Iowa. https://doi.org/10.2307/1565343
Sonawane H, Shelke D, Chambhare M, Dixit N, Math S, Sen S, Borah SN, Islam NF, Joshi SJ, Yousaf B (2022) Fungi-derived agriculturally important nanoparticles and their application in crop stress management–Prospects and environmental risks. Environ Res. https://doi.org/10.1016/j.envres.2022.113543
Srinivas C, Devi DN, Murthy KN, Mohan CD, Lakshmeesha T, Singh B, Kalagatur NK, Niranjana S, Hashem A, Alqarawi AA (2019) Fusarium oxysporum f. sp. lycopersici causal agent of vascular wilt disease of tomato: Biology to diversity–A review. Saudi J Biol Sci 26(7):1315–1324. https://doi.org/10.1016/j.sjbs.2019.06.002
Strobel G (2018) The emergence of endophytic microbes and their biological promise. J Fungi 4(2):57. https://doi.org/10.3390/jof4020057
Supaphon P, Phongpaichit S, Rukachaisirikul V, Sakayaroj J (2013) Antimicrobial potential of endophytic fungi derived from three seagrass species: Cymodocea serrulata, Halophila ovalis and Thalassia hemprichii. PLoS ONE 8(8):e72520. https://doi.org/10.1371/journal.pone.0072520
Szabados L, Savouré A (2010) Proline: a multifunctional amino acid. Trends Plant Sci 15(2):89–97
Thipyapong P, Hunt MD, Steffens JC (1995) Systemic wound induction of potato (Solanum tuberosum) polyphenol oxidase. Phytochemistry 40(3):673–676. https://doi.org/10.1016/j.tplants.2009.11.009
Van Loon L, Bakker P, Pieterse C (1998) Systemic resistance induced by rhizosphere bacteria. Annu Rev Phytopathol 36:453–483. https://doi.org/10.1146/annurev.phyto.36.1.453
Wani ZA, Ashraf N, Mohiuddin T, Riyaz-Ul-Hassan S (2015) Plant-endophyte symbiosis, an ecological perspective. Appl Microbiol Biotechnol 99(7):2955–2965. https://doi.org/10.1007/s00253-015-6487-3
Yan L, Zhu J, Zhao X, Shi J, Jiang C, Shao D (2019) Beneficial effects of endophytic fungi colonization on plants. Appl Microbiol Biotechnol 103(8):3327–3340. https://doi.org/10.1007/s00253-019-09713-2
Zou YN, Wu QS, Kuča K (2021) Unravelling the role of arbuscular mycorrhizal fungi in mitigating the oxidative burst of plants under drought stress. Plant Biol 23:50–57. https://doi.org/10.1111/plb.13161
Acknowledgements
The authors would like to thank the Botany and Microbiology Department, Faculty of Science, Al-Azhar University for promoting this research.
Funding
Open access funding provided by The Science, Technology & Innovation Funding Authority (STDF) in cooperation with The Egyptian Knowledge Bank (EKB). Not applicable.
Author information
Authors and Affiliations
Contributions
Conceptualization, AMA, MHK, AHH, MHS and MSA. Methodology, AMA, MHK, AHH, MHS and MSA; software, AMA, MHK, AHH, MHS and MSA; formal analysis, AMA, MHK, AHH, MHS and MSA. Investigation, AMA, MHK, AHH, MHS and MSA. Resources, AMA and MSA; data curation, AMA and MSA; writing—original draft preparation, AMA, MHK, AHH, MHS and MSA; writing—review and editing, AMA, MHK, AHH, MHS and MSA; supervision, AMA, MHK, AHH, MHS and MSA. All authors have read and agreed to the published version of the manuscript. All authors read and approved the final manuscript.
Corresponding author
Ethics declarations
Ethics approval and consent to participate
All authors approved.
Consent for publication
All authors agree for publication.
Competing interests
The authors declare that they have no competing interests.
Additional information
Publisher's Note
Springer Nature remains neutral with regard to jurisdictional claims in published maps and institutional affiliations.
Rights and permissions
Open Access This article is licensed under a Creative Commons Attribution 4.0 International License, which permits use, sharing, adaptation, distribution and reproduction in any medium or format, as long as you give appropriate credit to the original author(s) and the source, provide a link to the Creative Commons licence, and indicate if changes were made. The images or other third party material in this article are included in the article's Creative Commons licence, unless indicated otherwise in a credit line to the material. If material is not included in the article's Creative Commons licence and your intended use is not permitted by statutory regulation or exceeds the permitted use, you will need to obtain permission directly from the copyright holder. To view a copy of this licence, visit http://creativecommons.org/licenses/by/4.0/.
About this article
Cite this article
Abdelaziz, A.M., Kalaba, M.H., Hashem, A.H. et al. Biostimulation of tomato growth and biocontrol of Fusarium wilt disease using certain endophytic fungi. Bot Stud 63, 34 (2022). https://doi.org/10.1186/s40529-022-00364-7
Received:
Accepted:
Published:
DOI: https://doi.org/10.1186/s40529-022-00364-7